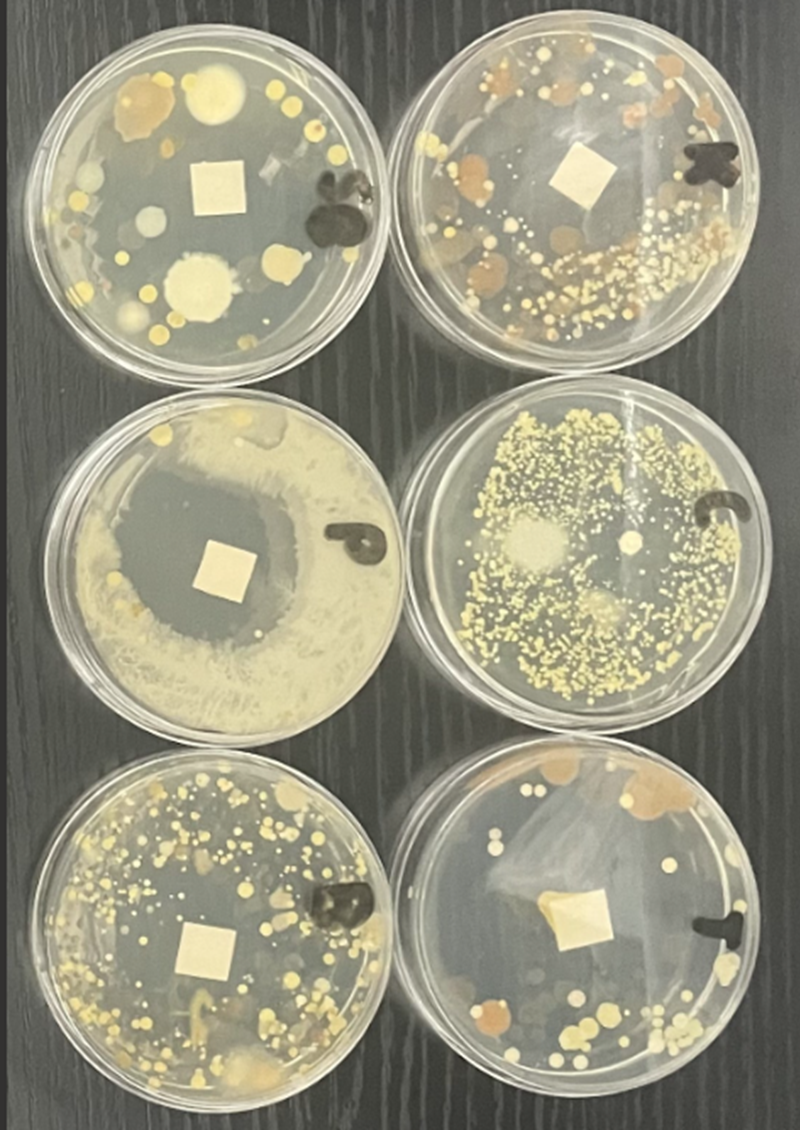

Discover amazing projects
Get inspired by the world of STEM with fantastic projects from The Big Bang Competition.
Whether you're interested in improving our mental well-being, exploring the extraterrestrial, or creating sustainable solutions - our young scientists and engineers have done incredible work!
Got a project?
Enter the Big Bang Project Gallery
Supported by
![]()


A Theme Park for the Future 2025
- Climate change
- Energy
- Sustainability
Our project was to come up with a sustainable a theme park.

A Theme Park for the Future 2025
- Climate change
- Energy
- Sustainability
Our project was to come up with a sustainable a theme park. We decided to design, create, develop and test a water wheel that could produce electrical energy. We also considered our park location, layout and logo along with design a website.
We decided to do this project as we are all passionate about saving our planet from global warming and climate change. One of our team members is a roller coaster enthusiast! Throughout our project we developed lots of skills like; communication, teamwork, project management, time management, presentation, report writing and researching. We also learned a lot about the laws of conservation of energy, the design process, and renewable energy sources.
Our favourite part of this project was the testing and designing of our water wheel. You can look at our website to see how it works!

ARPS for Tinnitus
- Digital technology
- Health & medicine
Tinnitus makes people hear ringing or buzzing in their ears, and we wanted to find a real cure!

ARPS for Tinnitus
- Digital technology
- Health & medicine
Tinnitus makes people hear ringing or buzzing in their ears, and we wanted to find a real cure. That’s why we've created ARPS (Advanced Repair and Prevention Surgery). First, we designed tests to find the cause of tinnitus in each person. Then, we planned a surgery using nano-lasers and stem cells to fix the problem safely. We also made sure the surgery is stress-free, especially for kids. ARPS is a new way to stop tinnitus for good, and we hope it can help people get their hearing back!
We were inspired by Uma and Andrew Gordon from Sai Fertility Clinic, who didn’t just treat infertility, but they also tackled the root causes. Their approach helped thousands of women in Andhra Pradesh, India, become mothers, and they even opened a hospital and charity to support those in need. That same mindset drove us to take on tinnitus. One of our team members, who’s passionate about ENT, wanted to find a real solution, not just a way to manage it. After seeing how much our maths teacher struggled, we worked together to create a structured approach that could address tinnitus at its source because the best way to help isn’t just to manage a problem, but to solve it.
Our favourite part was seeing how everything connected. The medicine, maths, and physics all came together to solve a real problem. Our team member who’s passionate about ENT, loves maths and all sciences, and loved learning how sound waves affect the ear and how different treatments could actually reset or heal the auditory system. Our other team member, who also loves maths and physics, enjoyed figuring out the precise calculations behind sound interference and how medical imaging could pinpoint problem areas. But more than anything, we loved the feeling of creating something that could genuinely help people. Seeing our idea take shape, knowing it had the potential to make a real difference. That was the most exciting part!

AI Prototype to help waste management
- Digital technology
- Environment
My project is aimed to tackle the ever growing mismanagement of waste materials around the world.

AI Prototype to help waste management
- Digital technology
- Environment
My project is aimed to tackle the ever growing mismanagement of waste materials around the world. Whether that be from space junk to ocean plastic to landfill, we need a better way to make sure that materials that can be repurposed or replenished in anyway are done. My project used the current evolving use of AI to help implement it into rovers that can be used in space or on land to help scan and detect recyclable materials with the help of human workers and engineers. This will allow for a more accurate and less time consuming process for the workers and in the long run help save many generations.
I have always been thinking about ways to make the world more sustainable and better to live in. A lot of people around the world face difficult conditions due to poor quality and lack of adequate technologies to help maintain their areas. On top of that, knowing that around 49% of plastics end up in landfill when they can be recycled or reused made me worried about the future generations and their availability on finite resources. With this I hope my project will be able to impact the lives of many who are suffering from the lack of resources from the growing demand and for the workers unable to sort through the pilings of trash and waste on both earth and space.
The most enjoyable part of making the prototype was being able to explore different ways of presenting my ideas through the mood board I had created into a final product. It took a lot of thinking and trialling and eventually I chose the designs I really liked. Throughout this process researching was also one of the most interesting bits that I had to undergo. The plethora of facts that follow onto becoming trends gave me a real sense of the direction this world was heading, and it was important that people started thinking about active ways to solve this. That’s why I had fun through that as it showed me a side of the world which wasn't fully visual until now.

Autopill
- Digital technology
- Health & medicine
The Autopill: an automated tablet dispenser with built-in health monitoring.

Autopill
- Digital technology
- Health & medicine
The Autopill: an automated tablet dispenser with built-in health monitoring. The primary aim of the project was to create a tablet dispenser that would automatically drop tablets in to a vessel at set times of the day. I also wanted to include basic health monitoring as I could not find anything available that had that function built-in. I designed the form of the unit in solid works, built it as a 3D model, and then designed the interior mechanics and electrics around that. I inputted code in to an Arduino unit to provide linked up functionality between the motor to control the dispensing, alert sound and lighting and health monitoring linked to a front mounted screen.
Worldwide we have an aging population with significant numbers of our older people having dementia and memory problems. Most families (including mine) have someone who is affected by dementia. I wanted to create something that would make the process of taking tablets a little bit easier. I thrive on solving problems through engineering and design and I enjoy the creative process behind that. I think the challenge to design, engineer and construct something to help my family and/or the wider community would be enormously rewarding, particularly if the end result is something that can help day to day.
The initial idea for my project was formed from the challenges faced by a family member remembering to take medication. Through discussions and research I was able to form ideas for what might help make that easier. The most enjoyable part of the project for me was creating the initial design. The form of the unit was important to me and making that work with the practicalities of the user was both challenging and extremely rewarding. The best part of the project was seeing the finished result. Making it in 3D and seeing it all working together at the end brought the picture I'd created to life which was brilliant to see.

Can AI Diagnose Breast Cancer?
- Digital technology
- Education
- Health & medicine
I wanted to see if a simple AI tool could help doctors diagnose breast cancer more accurately.

Can AI Diagnose Breast Cancer?
- Digital technology
- Education
- Health & medicine
I wanted to see if a simple AI tool could help doctors diagnose breast cancer more accurately. Using a computer program called K-Nearest Neighbors (KNN), I tested how well it could tell the difference between harmless (benign) and dangerous (malignant) tumours by looking at cell shapes, like how round or bumpy they were. I tried different settings for the program (called K values: 1, 3, 5, 7, 9) to find the best one. The best result was 97.4% accuracy, almost as good as a doctor! I also made graphs to show how the AI made its decisions. This could help clinics diagnose cancer faster, especially in places with few specialists.
I chose this project because cancer affects millions of people, and early detection saves lives. When I learned that some places don’t have enough doctors to diagnose cancer quickly, I wondered if AI could help. A Science Buddies guide showed me the basics, but I wanted to make it even better by testing different settings. I love that coding lets me solve real-world problems, like helping doctors spot cancer sooner. Plus, I’ve always been curious about how machines "learn" from data. This project combined my interest in biomedical engineering and helping others.
The coolest part was seeing the AI "learn"! When I changed the K value, the results improved, and the graphs showed clear patterns, like how malignant cells were more jagged. I also loved debugging my code (fixing errors) because it felt like solving a puzzle. The biggest "wow" moment? When K=3 hit 97.4% accuracy, I couldn’t believe a simple program could work that well! It was exciting to think that my tweaks could one day help real patients. Plus, I learned that small changes in science can make a big difference!

Can the UK become net zero by 2050?
- Climate change
- Energy
- Sustainability
This project aims to decide which energy source(s) would be best to help the UK reach net zero by 2050.

Can the UK become net zero by 2050?
- Climate change
- Energy
- Sustainability
What is the best way for the UK to reach net zero by 2050? This is an ambitious goal, and the government is yet to announce many official plans, so this project aims to decide which energy source(s) would be best. We have looked at the cost, safety, scalability, practicality and future potential of each of our five energy sources (nuclear, solar, wind, tidal, and hydroelectric) to figure out which is the best to implement on a large scale in the UK.
This project always aimed to be a part of the effort to save the planet. We're all passionate about preventing climate change and - although we know there's not much we can do - this project allowed us to try to solve a key problem that the UK is facing, even though it won't directly affect the environment.
Every one of us on this team has enjoyed every aspect of this project, from working together to saving the environment. We especially have loved being able to work on a research project like this, and to apply our science skills (and science passion) on real life figures and scenarios.

Changing what we eat
- Climate change
- Food
- Sustainability
I aimed to show how diets could affect the environment and to conduct a comparison between meat and plant-based diets.

Changing what we eat
- Climate change
- Food
- Sustainability
I aimed to show how diets could affect the environment and to conduct a comparison between meat and plant-based diets.
I really want to help the environment as I know that if we carry on the way we do then we will destroy our planet, I also care about animals very much and believe that they should not be farmed. I am vegan and I am hoping that the results from my report may influence other peoples diets.
I enjoyed finding out new information about diets and there impacts on the environment, I also enjoyed drawing the planet to show just how affected the environment is due to diets.

Clean Air Alliance
- Climate change
- Digital technology
- Energy
- Environment
- Food
This project is based around the idea to filter excess greenhouse gases into oxygen while creating underground gardens.

Clean Air Alliance
- Climate change
- Digital technology
- Energy
- Environment
- Food
This project is based around the idea to filter excess greenhouse gases into oxygen while creating underground gardens. These gardens will then be used to support homeless shelters by providing fresh produce, skill training, and a sense of community.
Our project is inspired by the need to reduce greenhouse gases and improve the ecosystem, particularly benefiting individuals with asthma. Greenhouse gases not only harm the planet but also contribute to serious health issues. We believe addressing this problem is crucial, and we are motivated by the potential to make a significant impact on both the environment and the well-being of the people who depend on it.
The best part of this project was working as a team to bring our idea to life. We loved sharing creative ideas, improving our plans, using new technology and watching our project grow into something that could help others. Working together helped us learn from each other, develop new skills, use our strengths, and create something that makes us proud.

Colour Recoginizing AI
- Digital technology
Our Big Bang project is an AI that is able to identify colours through a camera lens, specifically, ones that often appear in food tests.

Colour Recoginizing AI
- Digital technology
Our Big Bang project is an AI that is able to identify colours through a camera lens, specifically, ones that often appear in food tests. This will be to aid people who are colourblind to work in science. It will be helpful as it will identify the colours for them, in order to gain meaningful insight into their testing results, as well as help them in recognising data, as many methods of recording data use colours to represent it.
One of our friends is colour blind and he wants to be a scientist in chemistry when he is older. So we decided to design our project to help him, and people like him, recognise colours when they may not be able to easily by themselves. With our project there doesn't need to be someone with them all the time making sure that solutions are the correct colour and that they won't harm them in any way, giving them a sense of freedom as they can do it on their own.
Making the AI was fun as it was a lot of trial and error and in the early stages - we found the results very entertaining as it would sometimes get the colour very wrong, so we fixed it but it came up many times and it was fun to do. Also the brain storm was fun as we came up with lots of ways to do it. We also asked the advice of one of our Science Prefects at our school how we could do it.

CyanoMars
- Climate change
- Environment
- Space exploration
My project is called CyanoMars, and it’s about using bacteria to help make Mars more liveable for future space missions.

CyanoMars
- Climate change
- Environment
- Space exploration
My project is called CyanoMars, and it’s about using bacteria to help make Mars more liveable for future space missions. Since Mars has almost no oxygen, I wanted to test if Cyanobacteria (which can turn carbon dioxide into oxygen) could survive in Mars’ environments and actually produce oxygen. To do this, I built a sealed chamber that mimics Mars by adding CO₂ and tracking gas levels with sensors. This lets me see if the bacteria were actually working. If something like this worked on a larger scale, I could help astronauts breathe on Mars without needing to bring as much oxygen from Earth. It’s a small experiment, but it shows how biology could help us colonize other planets is the future.
I’ve always loved space, or anything that got me off the ground like planes. If I ever get the chance to go skydiving, I’d do it in a heartbeat! Space has always felt like the ultimate version of that. The idea that humans could one day live in space fascinates me, so I wanted to explore how we could make that possible. Instead of waiting for the future, I decided to take matters into my own hands and test whether Cyanobacteria could help make Mars liveable. I’ve loved science since primary school, and I’ve always enjoyed building things, so this project felt like the perfect mix of both. I wanted to challenge myself by designing and experimenting without a strict guide. More than anything, I wanted to see if I could think like a real engineer or scientist, solving problems and that could make a difference for the future.
I think the best part of this project was definitely how my family started expressing interest along the way. My mum helped me with the gas system, which was a big part of the project, and we figured out a lot of things together. My little sister became really fascinated by the idea, asking many questions about Mars and how such a small organism can change the structure of a whole planet. It was amazing to see how something I was working on could get my family so interested and excited. Another part was seeing my idea come together. What started as just an idea turned into a real project with adding the carbon dioxide, tracking the levels and watching everything work as planned. It felt really rewarding to see it all turn into reality, especially knowing my family was there supporting me through it.

DIY Bioplastic From Kitchen Waste
- Environment
- Materials & textiles
- Sustainability
My project focused on creating a biodegradable plastic using simple kitchen ingredients like corn-starch, honey, and apple cider vinegar.

DIY Bioplastic From Kitchen Waste
- Environment
- Materials & textiles
- Sustainability
My project focused on creating a biodegradable plastic using simple kitchen ingredients like corn-starch, honey, and apple cider vinegar. I wanted to find a way to reduce plastic waste by making a sustainable alternative that could break down naturally, rather than sticking around in the environment for hundreds of years. To make the bioplastic, I mixed the ingredients, heated them until thickened, and then poured the mixture into a mould to dry. Once it hardened, I tested it for flexibility, strength, water resistance, and biodegradability. The results showed that while the plastic was flexible and biodegradable, it wasn’t strong enough for heavy use and didn’t hold up well in water. Although there were some limitations, the project proved that it’s possible to make a basic bioplastic at home using natural ingredients. It was a great way to explore sustainable materials and think about practical solutions to plastic pollution.
I’ve always been passionate about finding ways to reduce waste and protect the environment. Plastic pollution is a massive problem, and I wanted to explore how simple, everyday ingredients could be turned into something useful. I’d seen a few videos and articles about homemade bioplastics, and it got me thinking about whether I could make my own version. I liked the idea of using stuff most people already have at home because it makes the idea more accessible to anyone who wants to try it. Plus, it’s great to know that we can take small steps towards solving big problems with a bit of creativity and some basic science. It was really rewarding to see my experiment come together and actually produce a flexible, biodegradable plastic. Even though it wasn’t perfect, it felt good to know I was making something that could potentially make a difference in reducing plastic waste.
The best part of this project was definitely seeing the bioplastic actually take shape and feel like real plastic. I was a bit sceptical at first about whether it would work, but when it hardened and I could bend it without it snapping, it was really satisfying. Another great bit was testing the plastic to see how well it held up. Some tests didn’t go as planned, like when it didn’t resist water as much as I’d hoped, but I still learned a lot from seeing how the material responded. It made me realise how much trial and error goes into developing sustainable alternatives. Overall, I really enjoyed getting hands-on with the experiment and learning through doing. It was exciting to make something from scratch and think about how it could be improved in the future. It definitely made me want to explore more eco-friendly ideas.

Edible Bottle
- Environment
- Food
- Materials & textiles
- Sustainability
In order to tackle the plastic pollution crisis, I aimed to create a unique solution, one in which intrigues people to take a closer look and to interact with the product.

Edible Bottle
- Environment
- Food
- Materials & textiles
- Sustainability
Cleaning the oceans, one sip at a time! Globally, 500 Billion bottles are thrown away each year, with only 12% of which being recycled. 8 Million tonnes of plastic waste created from bottles end up in the ocean each year. The average British resident creates 94.4kg of CO2 each year from using disposable plastic bottles. So, what if instead eat away the plastic waste we create? In order to tackle the plastic pollution crisis, I aimed to create a unique solution, one in which intrigues people to take a closer look and to interact with the product. This approach aimed to be more effective then traditional methods as people would willingly interact and enjoy this alternative, as opposed to being a compromise to traditional bottles.
I was first inspired to begin this project after seeing this unique solution to the growing plastic waste issue. Having cutlery you could eat not only minimises plastic waste, but also adds an interesting element to meals. I was inspired through my research of other designs: Ooho 'Edible Water Balls' are balls of water contained in a skin of sodium alginate. Ooho also made alternatives to PFA plastics used for paper food containers, derived from seaweed, called “Notpla”. Sorbos Edible Straws, a fun and tasty alternative to plastic or paper straws, with a variety of different flavours to select. These straws are individually paper wrapped, producing no plastic waste. 'Cupffee Edible Coffee Cups' were another inspiration: an edible coffee cup made of oat bran and wheat flour and sodium alginate It has a recommend shelf life of 12 months, the cup lasts for around 40 minutes before it may begin leaking.
Overall, I really enjoyed the problem solving aspect of this project, how at each step of the process, I encountered new challenges I needed to find a solution for using a limited range of equipment and time and I believe my project, while not perfect, was successful in many areas.

Effect of UV on the antimicrobial action of TiO2
- Environment
- Health & medicine
The aims of this project were to investigate how the different UV lights can help titanium dioxide kill germs such as COVID and to use the results to design an air filter with UV and titanium dioxide to clean the air indoors.

Effect of UV on the antimicrobial action of TiO2
- Environment
- Health & medicine
During the COVID-19 pandemic while searching for vaccines, considerable effort was made to develop ever more powerful technologies to stop the spread of airborne microorganisms like COVID in indoor spaces. UV-based and photocatalytic oxidation (PCO)-based technologies (i.e., the combined action of ultraviolet (UV) light and photocatalytic materials such as titanium dioxide (TiO2)) were investigated because they are cost-effective and eco-friendly. The aims of this project were to investigate how the different UV lights can help titanium dioxide kill germs such as COVID and to use the results to design an air filter with UV and titanium dioxide to clean the air indoors. Results showed that UVA was the most effective at helping titanium dioxide kill germs followed by UVB and then UVC. It was decided to use UVA in the air filter.
During the COVID-19 pandemic considerable effort was put in to develop more powerful technologies to restrict the spread of airborne microorganisms in indoor spaces. This was necessary to prevent the spread of the disease. UV light was known to kill viruses and bacteria but if it's combined with titanium dioxide, it's even better. I investigated how titanium dioxide in the presence of UVA, UVB and UVC light acts as an antimicrobial against e.coli 12. My aims were to investigate the effect of UVA, UVB and UVC light on the antimicrobial ability of titanium dioxide on e.coli 12 and determine which would UV would be best to use in an air filter with TiO2 to kill viruses and bacteria. Ultimately, I would use my results to design an air filter that could be made available to the public for use in indoor spaces to clean the air.
I enjoyed researching, designing and carrying out my own project. The experimental work was particularly enjoyable as I enjoy doing practical work. I also designed and constructed my own light boxes. I had fun! As the project had a real life application, I felt that I was contributing to society. I will continue the project by actually designing and making my own air filter incorporating TiO2 and UVA which can be used in enclosed places to protect against and remove pathogens and improve the air quality in inside spaces like homes, offices, schools, shops, businesses and hospitals.

Firestorm Protector
- Climate change
- Environment
The recent devastating wildfires in Los Angeles sent shock waves around the world. This project aimed to explore why homes and business properties are so vulnerable to wildfires and what can be done to better protect them in the future.

Firestorm Protector
- Climate change
- Environment
The recent devastating wildfires in Los Angeles sent shock waves around the world. With over 16,000 homes and businesses destroyed and 29 lives lost, they were a wake-up call for what is becoming a more severe and ever more frequent event in many countries around the world. This project aimed to explore why homes and business properties are so vulnerable to wildfires and what can be done to better protect them in the future. To learn more, I searched online to find out how properties are currently protected from wildfires and why so many are destroyed. Once I understood this more clearly, I identified other approaches, selected the best one, designed and built a prototype and tested it. My analysis of the results showed that my best idea is novel and has significant potential but requires further development if it is to become commercially viable.
The motivation for this project comes from having family relatives who live near to Los Angeles. I simply could not think of a better project to do, and it was also an opportunity to spend some time with my grandfather. He is an engineer who likes to invent things and I have always been fascinated with what he does and would love to learn more about the practical side of engineering and technology. When I started to search online about wildfires, I discovered so much about them, how widespread they are becoming and the devastation they are causing to towns, villages and the surrounding habitat that is so critical to wildlife survival globally. This problem is so big that it has made me so passionate about the topic that I am determined to find ways to better protect properties and wildlife / habitats.
This is the first project that I have done like this, and I have enjoyed every bit of it. I think that because it is a new experience for me that it has been extra special and by using a logical step by step process it has made it much easier to understand. Having said that, I would say that the bits of the project that stand out as being most enjoyable have been finding out about what wildfire protection systems are currently available to buy and coming up with creative new ideas that might me more effective and more environmentally friendly. In addition to being creative I have also really enjoyed the testing of my prototype to see how well my best idea worked as well as what refinements I may be able to make to get it to work even better in the future.

Growth Guardian
- Digital technology
- Food
- Sustainability
Our project is inspired by the global Sustainable Development Goal 2, 'ZERO HUNGER'. Our aim was to improve agriculture and use AI to help grow plants in aeroponic/hydroponic systems in small spaces.

Growth Guardian
- Digital technology
- Food
- Sustainability
Our project is inspired by the global Sustainable Development Goal 2, 'ZERO HUNGER'. Saving lives was our goal, as from research we found, on average 2.4 billion people have no access to safe, nutritious food, which led to malnutrition or increased death rates. Our aim was to improve agriculture and use AI to help grow plants in aeroponic/hydroponic systems in small spaces. This involved making a 2D and 3D model of our AI robot, carefully considering its dimensions and materials for body parts. The features of the robot needed to be able to provide nutrients and air for growth. Both arms were designed to have different functions to meet the needs of aeroponics and hydroponics. The eyes were used as sensors, to emit ultrasound waves.
Our project was inspired by the ongoing issues with growing crops in poor countries, especially those that have limited access to clean water and food. Through our research, we have identified vertical farming, a sustainable approach to agriculture that can increase crop yield in short periods of time, as well as reduce carbon emissions. Through this project we have learnt how to work as a team and have developed a prototype solution that monitors the condition of crops.
The most enjoyable part of the project was designing different robots and then taking the best features from each and combining it into our final robot that we are proud of. We also enjoyed researching about hydroponic and aeroponic systems, as this was something new to us and we learned about new ways to grow crops.

Health Hub
- Health & medicine
- Humanitarian
For my project, I aimed to create a self-sustaining medical hub that could be used in remote, underserved areas.

Health Hub
- Health & medicine
- Humanitarian
For my project, I aimed to create a self-sustaining medical hub that could be used in remote, underserved areas. These areas often struggle with limited access to healthcare, clean water, and electricity. My goal was to design a portable, solar-powered device that provides essential healthcare services and addresses waterborne diseases. I achieved this by researching existing solutions, designing the device, and selecting affordable, durable materials. The end result was a multi-functional health hub that is cost-effective, portable, and easy to use in rural communities.
I was inspired to focus on healthcare accessibility after learning about the struggles faced by people in remote areas from a Geography documentary in school, where lack of clean water, electricity, and healthcare leads to preventable deaths. I wanted to find a way to help solve these problems and improve healthcare in these communities. I’m passionate about using my skills in design and problem-solving to create practical solutions that can make a real difference in people’s lives. The opportunity to create something that could have such a positive impact on global health motivated me to pursue this project.
The best part of working on this project was seeing my ideas come to life in sketches and drawings. It was exciting to realize that the Health Hub could actually help improve the lives of people in rural communities. I also enjoyed the process of researching and designing the device, as it gave me the chance to develop my skills in problem-solving and design. It was rewarding to know that my project could potentially solve real-world challenges and make a lasting difference!

Help Drones
- Environment
We focused on trying to help people in poorer countries gain access to food, sanitation and even medical equipment.

Help Drones
- Environment
We focused on trying to help people in poorer countries gain access to food, sanitation and even medical equipment. These can be very big problems as people in these countries cannot always have these things regularly. The main problems are hunger, hygiene and health. Our aim is to offer help to these problems, hence the name 'Help Drones'. A reason sanitation is so important is due to the fact that the lack of it is the main cause of disease and the spread of it. We would also have unique disaster relief drones that would be equipped with a radio and heat sensor to help rescue teams find those in need after a natural disaster.
In 2023 alone there was a overall death toll of 95,000 from natural disasters, our drones could be turned into relief drones with heat sensors and walk talkies to make sure search teams don’t leave anyone behind. We hope that if our idea was in place some of these deaths could have been prevented. 5.8 million people have died from hunger only this year. Our idea will help prevent this.
The best bit of this project was working together as a team!

How Predicative AI can save the oceans
- Digital technology
- Sustainability
- Water
Our project is all about using Predictive AI to fight illegal fishing, which is a huge problem for marine life and fishing industries.

How Predicative AI can save the oceans
- Digital technology
- Sustainability
- Water
Our project is all about using Predictive AI to fight illegal fishing, which is a huge problem for marine life and fishing industries. By combining AI with satellite imagery and data, we can predict and catch illegal fishing before it happens. Our AI model, based on Random Forest Regressor, looks at ship data like speed, fishing spot, and distance from shore to figure out if it activity is illegal. We also looked into using drones and underwater tech to allow more data and accuracy. We want to help protect the ocean for future generations and to preserve earth's biodiversity.
The inspiration behind our project comes from the urgent need to protect our oceans from illegal fishing, which is a global issue affecting marine ecosystems and coastal communities. As we learned that illegal fishing accounts for about 20% of global catch, we were shocked by the devastating impact on endangered species, as well as the livelihoods of people who rely on sustainable fishing practices. Motivated by this challenge, we wanted to make a real difference. Our goal was to use AI to predict illegal fishing activities before they happen, instead of simply reacting after the event. We were passionate about using technology creatively to solve this problem and saw the potential for our project to prevented illegal fishing. Through teamwork, research, and the innovative application of AI, we are determined to contribute to a sustainable future for both the oceans and the communities that depend on them.
The best part of working on this project was definitely seeing how all our ideas came together to make a real difference. I loved how we used AI to predict illegal fishing before it even happened; it felt super exciting knowing that our work could help protect marine life and support coastal communities. Collaborating with my team was another highlight. We had different ideas, and it was awesome bouncing them off each other and finding solutions to such a huge problem. I also really enjoyed the fact that we were using our skills and embracing the new and exciting world of AI to tackle an actual environmental issue. When we saw our model making predictions that were spot on, it was such a cool moment. It felt like all the hard work was actually making an impact and helping us move toward a better future.

Investigating AMR in Household Bacteria
- Health & medicine
My project aims to investigate the potential for bacteria in the home to become resistant to disinfectants by testing growing bacteria from different locations in my house.
Investigating AMR in Household Bacteria
- Health & medicine
My project aims to investigate the potential for bacteria in the home to become resistant to disinfectants by testing growing bacteria from different locations in my house (with different locations being cleaned with disinfectants more/less often than others), with a disinfectant square of paper placed in the centre, to see how effective the disinfectant was at killing the bacteria. Resistance to disinfectants is an increasingly significant issue, both in home environments and in laboratory, hospital, veterinary and a multitude of other settings, intriguing me on whether or not it should be considered to be an issue in my own home!
The research I conducted during the course of my project has not only intrigued me, but has also heavily opened my mind on the issue of bacteria having the ability to resist not only antibiotics, but also other antimicrobial agents, which may seem like a glaring fact, but it was one that had never struck my mind. Throughout my life, I had heard of the dangers of overusing antibiotics, but now I feel that it is equally as valuable to be educated on the dangers of overusing disinfectant since cleaning with harsh disinfectants is part of the cleaning routine of many.
For me, the best part of my project was the process of growing and culturing my different bacteria samples, seeing them grow everyday and getting home from school to see how much they had grown from the previous evening.

Green Cube
- Climate change
- Food
- Sustainability
This project focused on developing a small, automated greenhouse using a clear plastic bin and a Raspberry PI.

Green Cube
- Climate change
- Food
- Sustainability
This project focused on developing a small, automated greenhouse using a clear plastic bin and a Raspberry PI. The system maintains optimal growing conditions through the use of moisture, temperature and humidity sensors which are internally connected to watering pumps, a fan, heaters and LED UV lighting. The aim of the project is to create a self-regulating environment for optimal plant growth in areas with harsh environments or limited resources. Following the conclusion of the project, we wanted to continue building our idea, aiming for a system that successfully maintained stable conditions, with automated watering and ventilation responding to humidity and temperature changes. However we fell just short of this due to coding complications. This project could be scaled up to support sustainable food production, agricultural research or even conservation of rare plants.
We knew that as the next generation of engineers, a big part of our job will be engineering a better future. So why not start now .The project started when one of the team member's parents brought up how they find it hard to find the perfect place indoors for different plants to thrive. They said a project/product that helps identify a plants environmental requirements would be helpful. We agreed this was a good starting point, but took it one step further and decided to create a project that made these ideal conditions portable. The project was tough but helped us develop skills that have already helped our current education but that will also aid our STEM future.
The best part of the project for us all was the in-depth problem solving we undertook to bring this idea to life. This project is heavily grounded in engineering, an area we are all invested and interested in, and so getting a taste of this was so exciting. The group problem solving to help us create and fix the project was so in-depth, and it made us all more confident problem solving outside of the project. The feeling of planning/designing a project and then creating it, and getting hands on in it's assembly is amazing. And the experience of doing it with friends made the project even more fun and helped us create a promising end result!

Light and Polarisation
- Education
In my project I explored the complex world of light, from experimenting with polarising filters to trying to comprehend Maxwell's equations to gain a better understanding of light.

Light and Polarisation
- Education
In my project I explored the complex world of light, from experimenting with polarising filters to trying to comprehend Maxwell's equations to gain a better understanding of light.
Did you know something as simple as light polarisation is used across many different fields? For instance in cryptography, where quantum randomness in light polarisation can be used to generate random numbers. Or perhaps quantum computing, or maybe even stress analysis using the principles of photoelasticity. Isn't it COMPLETELY BONKERS that this one basic principle can be used for so much!
This project allowed me to be free from school's pressure and research and do what I love. I was able to research whilst at last getting my hands dirty doing some real science!

Mental Health in Agriculture
- Health & medicine
The objective of our project is to study the impact of poor mental health in agriculture and look at the stresses of a farming life, with particular emphasis on the younger generation since they are the future of farming.

Mental Health in Agriculture
- Health & medicine
The objective of our project is to study the impact of poor mental health in agriculture and look at the stresses of a farming life, with particular emphasis on the younger generation since they are the future of farming. Throughout our investigation we look closely at the underlying factors that contribute to poor mental health in farmers, what help and support is available for them to avail of, and how successful this is in enabling young people to navigate the stresses of an agricultural life whilst keeping their mental health as a priority.
We are all from the farming community and this issue is close to our hearts and impacts our lives daily. A snapshot of some of the findings we discovered through our own research is:
● The younger generation of farmers struggle more with their mental health compared to the older generation.
● Many farmers feel isolated on their farm.
● There is still a significant stigma around mental health, particularly amongst men.
● There are approximately 25,000 individual farmers here in the north of Ireland who work alone.
● Up to 94% of farmers under the age of 40 say that poor mental health is one of, if not the biggest hidden danger in farming today.
We were committed to trying to understand better the issues and get conversations started.
We loved working on this project. It is safe to say that we have changed as we have journeyed through this. Our confidence has increased, we can communicate with our peers and adults much better. We have become better at working to deadlines and have been able to produce relevant and interesting work. We have enjoyed working as a team and, as friends, we have had great fun throughout.

Music, Cognition and Concentration
- Education
- Health & medicine
As a group we designed and experiment to test our hypothesis that 'listening to music may benefit students in school environments by boosting their mental ability and helping them focus'.

Music, Cognition and Concentration
- Education
- Health & medicine
As a group we designed and experiment to test our hypothesis that 'listening to music may benefit students in school environments by boosting their mental ability and helping them focus'. We designed and carried out an experiment on 30 volunteer students, testing them on a puzzle task with music and without music. Our data supported our ideas of music affecting mood and concentration because each task score increased with music. Our results could be used to help students study or in exams to improve their performance and grades.
As a group we are all very interested in music and we wanted to find a project that we could apply it to in a scientific way. This led us to psychology and the way our brains could interpret and respond to music.
We thought the most fun part of our project was the actual experiment; we enjoyed working with each other to execute our ideas and see them come to fruition!

Now You See Me Too
- Digital technology
- Transportation
My project is a smart headphone system designed to help users stay aware of their surroundings while wearing headphones.

Now You See Me Too
- Digital technology
- Transportation
My project is a smart headphone system designed to help users stay aware of their surroundings while wearing headphones. The device uses a small camera to detect objects like dogs, people, cars, and bikers. When something is detected, it sends a notification to the user’s phone, plays a matching sound (like a dog bark for a dog), and flashes an LED light in their peripheral vision. This system helps users recognize nearby objects without removing their headphones, improving safety. My goal was to create a simple, effective way to keep people aware of their environment, and my final result is a working prototype that successfully detects and alerts users in real time.
My inspiration for this project came from my love for technology and my interest in solving real-world problems. I noticed that many people wear headphones while walking or biking, often becoming unaware of their surroundings, which can lead to accidents. I wanted to create a solution that keeps users safe while allowing them to enjoy their music. This project also gave me a chance to develop my creativity and problem-solving skills by designing a system that combines object detection with real-time alerts. My goal was to make everyday life safer, and I’m excited that my project could help people stay more aware of their surroundings without changing their habits.
My favourite part of this project was bringing my idea to life and seeing it work in real-time. It was exciting to code the camera and test how it could detect different objects, then trigger the right sound and visual alerts. I also enjoyed the problem-solving aspect; figuring out how to make the system accurate and responsive was challenging, but fun! It was rewarding to watch everything come together and know that this device could help people stay safe while wearing headphones.

Probiotic Power
- Food
- Health & medicine
For my project, I wanted to compare how different probiotics like Kefir, Greek Yogurt, and others affect digestion and bloating.

Probiotic Power
- Food
- Health & medicine
For my project, I wanted to compare how different probiotics like Kefir, Greek Yogurt, and others affect digestion and bloating. Over two weeks, I tested six people aged 35-45, giving each one a different probiotic to try. They recorded their digestion and bloating levels each day on a scale from 1 to 5. After two weeks, I found that Kefir and Greek Yogurt showed the best results, with people feeling no bloating and much better digestion. The people who used Natural Yogurt or **Supplements** saw some improvement, but not as much. I plan to expand this project in the future by testing different types of yogurt, like sweet and sour, and studying how acidity affects digestion. This could help others improve their gut health naturally and avoid bloating.
My inspiration for this project comes from my grandmother, who always ended her lunch with curd rice, a common dish in India. She believed in its health benefits, and I’ve noticed that previous generations didn’t face health issues like cancer as much as today. Growing up, I always felt that the power of curd was real. This led me to explore the effects of probiotics like Kefir and Greek Yogurt on gut health and digestion. Through this project, I learned how to manage people’s diets remotely. I had to track their progress without being physically present, ensuring they were accurately following the plan. This taught me how to communicate clearly, stay organized, and be responsible for managing a study. I also developed research skills, data analysis, and the ability to present findings effectively. It was a great experience that showed me the importance of gut health.
My favourite part of this project was definitely managing the diet, even though it was funny at times! Stopping my family from eating out and sticking to the probiotics was a bit of a challenge, but also fun. They kept asking if they could sneak in a burger or pizza, but I had to stay firm! What I enjoyed most was their support — they really helped me with the study, and it felt amazing knowing they were behind me. Their willingness to try different probiotics and be a part of my project was so encouraging. I’m really blessed to have such a supportive family, and it made the whole experience so much more enjoyable and meaningful.

Project Cerebra Nova
- Health & medicine
Our project explored the concept of whole-brain transplantation.

Project Cerebra Nova
- Health & medicine
Our project explored the concept of whole-brain transplantation. Initially, we sought to determine its technical possibility. However, we found that current scientific understanding reveals substantial complexities. The brain's intricate neural networks and vascular dependencies present significant obstacles. Furthermore, even if technically possible, profound ethical considerations arise. Questions regarding personal identity and consciousness necessitate careful deliberation. Diverse perspectives exist concerning the ethical permissibility of such procedures. Therefore, our focus shifted to a comprehensive analysis of the scientific and ethical implications, acknowledging the current limitations and the necessity for extensive future research.
I was trying to find out if it was even the tiniest bit possible to transfer a persons brain to the body of another. Personally, I am very passionate about this topic as I have always been so eager and curious about it since reading the story of Ben Carson who I adore. It amazed me how many people have died due to neurological illnesses like Multiple Sclerosis, Alzheimer's and more. This ignited a fire in me and with the help of my friends, I was able to come up with this idea that could one day be the answer to many medical questions in the future.
I loved working with my friends on this project because we just knew how to work together and our ideas just complimented each others so much! The team were excited for the opportunity to do some drawings, and my love for the brain just made the whole project even better!

Project Step
- Climate change
- Energy
- Environment
- Sustainability
Our project turns your footsteps into electricity!

Project Step
- Climate change
- Energy
- Environment
- Sustainability
Our project turns your footsteps into electricity! Special tiles (like puzzle pieces) press down when you walk, spinning a tiny generator inside, like a mini windmill powered by people that makes electricity! The more steps, the more energy we make to light up parks or charge phones. The tiles are springy (like a trampoline but safer) and won’t break because they’re made from super-strong recyclable plastic. We tested them in school and they lit LEDs easily! They’re designed for busy spots like malls or sidewalks, where lots of walking generates lots of free, clean energy. Why? To show that everyone can help the planet. Instead of coal or gas, we use something we do every day, walking! Plus, the tiles look really cool and teach kids how energy works. Imagine sidewalks that glow at night, powered by you!
Climate change is a global problem. Walking through crowded train stations, we wondered if the energy from footsteps power the lights above? This question sparked our project. We discovered that many renewable energy technologies are expensive or impractical for public spaces. Our goal became creating an affordable, modular system that communities could adopt easily. As a team, we combined creativity, designing, engineering and experimenting with springs and gears. Testing the tiles with classmates showed how even light pressing could light LEDs, proving that sustainability can be simple and engaging. We hope our project inspires others to rethink energy use, imagine sidewalks powering streetlights or schools using student movement to charge devices! By focusing on accessibility and education, we aim to spread the idea that sustainability starts with small, collective efforts. This project isn’t just about our design, it’s about empowering everyone to see their role in building a greener future.
The best part was seeing our idea come to life! When we pressed the first tile and the LED lit up, we were very happy! But even better was presenting to classmates. The idea we demonstrated to them, was invaluable. The were excited when they realised our idea actually worked, making a sustainable future seem more possible. We also loved the teamwork. Dividing roles for CAD design, 3D printing and wiring felt like the group really worked hard together to produce something that worked. We looked for fixes to problems together, like broken springs and failed prints. Through this we developed as a team, with a range of skills. Mostly, we’re proud that our tiles aren’t just a prototype and we can educate more people on sustainability. This project taught us that innovation isn’t just about circuits and springs… it’s about sharing ideas, one glowing LED at a time.

Rain Root
- Climate change
- Digital technology
- Environment
- Sustainability
- Water
Our project was to design the Rain Root, a self-watering plant pot that helps people care for their plants more easily and sustainably.

Rain Root
- Climate change
- Digital technology
- Environment
- Sustainability
- Water
Our project was to design the 'Rain Root', a self-watering plant pot that helps people care for their plants more easily and sustainably. We aimed to solve the common issue of forgetting to water plants, which often leads to unhealthy growth. The Rain Root uses felt “roots” that absorb water from a dish below and transport it into the soil, keeping plants consistently hydrated with minimal effort.
We began with background research, explored various materials, and tested different fabrics. We chose GumTec, a material made from recycled chewing gum, for its waterproof and eco-friendly properties. The final prototype is both functional and sustainable, using organic wool felt to support the water-wicking system. Our design encourages more people to grow plants at home while reducing waste and conserving water. The Rain Root offers a creative, practical, and environmentally responsible solution to everyday plant care.
The inspiration for our project came from a common problem, forgetting to water houseplants! Many people enjoy having plants but struggle to keep them alive due to busy routines or inexperience. We wanted to create a product that makes plant care easier and more reliable, especially for beginners.
We were also passionate about sustainability and wanted to explore how eco-friendly materials could be used in design. We were inspired by how waste, like recycled chewing gum, could be turned into something useful. This led us to discover GumTec, a recycled material that became the base of our product.
We chose this project because it combined creativity, environmental thinking, and problem-solving. It gave us the chance to experiment, learn how materials work, and design something that’s practical and responsible. Most of all, we wanted to encourage more people to grow and care for plants at home.
The best part of working on the Rain Root project was watching our idea grow into a real, working product. It was incredibly satisfying to go from a basic concept to a fully developed prototype that actually worked. We especially enjoyed experimenting with materials, testing different types of felt and learning about new, sustainable options like recycled chewing gum was both fun and eye-opening.
Working together as a team was also a highlight. We each brought different ideas and strengths, and it was great to collaborate, share feedback, and solve problems together. One of the most rewarding moments was seeing the felt actually draw water upward, it was a small success, but it showed that our design could work in real life.
This project gave us a chance to be creative, think practically, and make something that could have a positive impact!

Roboticoat
- Digital technology
- Health & medicine
I aimed to explore various ways in which technology and engineering can contribute to both inclusivity in science and helping people suffering with different conditions.

Roboticoat
- Digital technology
- Health & medicine
In this project I aimed to explore various ways in which technology and engineering can contribute to both inclusivity in science and helping people suffering with different conditions. These conditions included chronic back pain linking to spinal arthritis, amputation, paralysis, and congenital limb difference. My ideas to combat these conditions are mainly on the basis of my own knowledge of bionic technology, but also my creativity. Thus, through extensive research, I came up with Roboticoat, essentially a lab coat built in with specific features to help a person have greater accessibility to carry out different functions.
I focussed on this project due to my own personal experience with some of my peers suffering from various conditions hindering their daily activities. I wanted to create something that would help them carry out daily functions better, but also feel more a part of society. My passion for STEM contributed greatly to this, with the support of my opinion that STEM should be more accessible and inclusive to those less advantaged. Being a huge MARVEL fan also gave me some inspiration for the bionic designs through characters like The Winter Soldier and Doctor Octopus. Thus, I created Roboticoat.
I thoroughly enjoyed using my creativity to come up with and draw these designs. It was also very empowering knowing that I could possibly be helping my peers with their conditions. Overall, I just really loved completing this project!

School event lighting system
- Digital technology
- Education
"We must be able to do something more interesting," went the discussion of those running the sound and lighting for the school musical.

School event lighting system
- Digital technology
- Education
"We must be able to do something more interesting," went the discussion of those running the sound and lighting for the school musical. Most are members of the school electronics club and decided we should and could build some lighting effects in-house. Further conversations and investigations led the group to design and build a series of 50cmX50cm panels, each with a 30X30 grid of 'neopixel' LEDs. Every unit has its own microcontroller and the panels can be programmed and controlled remotely to present a colour, picture or animation. Running open-source WLED software on the microcontrollers means the panels can act as individual units or a larger display. So far we've built 6 panels and used them separately in one school production and most recently as a 1mX1.5m screen. More panels are under construction with plans for dazzling lighting to enhance the 'Teacher Karaoke' fundraiser next term.
During the school's production of 'Shrek' we were helping with the sound and stage lighting and we kept thinking of cool things we could do with the right kind of lights. We talked about it at the electronics club and one of the STEM ambassadors brought in something he had made using strips of 'neopixels' and we agreed that we could use that kind of thing to produce stage effects. And we decided that we could probably make them ourselves - that was what set the project rolling.
We've loved seeing something we made right from scratch being used in whole school events, especially when there are specific comments from audience members about the lights or lighting effects. Like lots of things, at the beginning we didn't fully appreciate how hard it would be to build the panels of LEDs and especially to 'trouble-shoot' them when they didn't quite work. The programming was also complicated but it means we have learned a lot of new skills. And the group works very well as a team so when new people join the club we are happy to share what we have learned and keep on learning new things as well.

SereniWrap: Medical baby blanket
- Health & medicine
- Other
Our product is called SereniWrap, and it is a baby swaddle that offers the benefits of skin-to-skin contact, while also providing soothing effects through heart beat vibrations.

SereniWrap: Medical baby blanket
- Health & medicine
- Other
Our product is called SereniWrap, and it is a baby swaddle that offers the benefits of skin-to-skin contact, while also providing soothing effects- through heart beat vibrations. The blanket wraps around the baby with Velcro, and has a heartbeat monitor on the 'paw'. We aimed to achieve this by delegating tasks to each member via their strengths. We managed to reach our end result through meticulous research on case studies and materials.
Our inspiration came from the empathy towards estranged babies, and then later towards all types of disadvantaged babies and mothers, too. We really enjoy designing products but also researching what the best materials are. Initially our group took on The Big Bang Challenge, since we wanted to participate in a science challenge. However by the end of The Challenge, we developed valuable skills of independence of perseverance. We also found that we became much more efficient when sorting tasks out between us to improve productivity. Overall it was extremely fulfilling to produce a product that could help people in real life.
We all really enjoyed working together as a team and brainstorming ideas. The debates we had as we chose an idea was really fun and we would definitely do it again! We liked the mix of creativity but also the research that went into it. Learning so many new and eye-opening facts made us extend our love for science past theory and in to the real world.

SmartNano Lenses
- Digital technology
- Health & medicine
- Materials & textiles
This project focuses on designing the next generation of AR contact lenses through conceptual engineering.

SmartNano Lenses
- Digital technology
- Health & medicine
- Materials & textiles
Imagine AR so seamless it feels like magic—no bulky headsets, no awkward screens. Just a nano-thin contact lens, powered by your body. Inspired by 'Warcross', this design features an atom-thick interface that harnesses bioelectricity—no batteries needed. Unlike standard AR, which overlays images, this lens interacts directly with the visual cortex, seamlessly projecting digital information into the retina itself. This project focuses on designing the next generation of AR contact lenses through conceptual engineering. Exploring advanced materials, bioelectric power, and neural integration allows to develop a simple structured blueprint. While current technology limits real-world production, the foundation for future innovation is possible. With applications in medicine, industry, and everyday life, this breakthrough could revolutionise human-computer interaction, including surgical precision and immersive learning. These lenses open a new era of augmented reality. The future of AR isn’t coming—it’s already in sight.
I chose this project because of my curiosity in nanotechnology and wearable technology, as well as the increasing demand for more advanced and accessible AR solutions. AR has the potential to transform how people interact with the digital-world, but current systems rely on bulky headsets or external devices, limiting their practicality for everyday use. This inspired me to explore an alternative that could incorporate AR seamlessly into daily life. While considering different wearable technology concepts, I evaluated smart glasses, biometric wearables, and even neural interface devices. However, each had limitations in terms of size, convenience, and user experience. AR-integrated contact lenses stood out as the most promising because they could provide an immersive digital experience without requiring cumbersome hardware. Combining nanotechnology with bioelectric power sources, these lenses could potentially offer a truly hands-free, unobtrusive AR experience, making them a compelling focus for my research and design exploration.
Overall, I gained a good understanding of the complexity of incorporating AR into wearable lenses. If I had more time and resources, I would focus on further research into suitable nano-films and microchips and investigate energy-efficient methods for powering these devices. I would explore the development of a working prototype to test and refine my design. If I were to do the project again, I would start with a deeper exploration of existing research and technologies in the AR and nano-tech space. I would also seek out more expert guidance or mentorship to ensure a more structured and efficient development process. The most enjoyable aspect of the project was the design phase, where I could creatively explore different methods of integrating AR into contact lenses and think through innovative solutions to the challenges I encountered. The hands-on nature of this process kept me engaged and motivated.

Solar Panel Phone Case
- Digital technology
- Energy
- Environment
- Sustainability
We have designed a phone case that can charge your phone using the sun.

Solar Panel Phone Case
- Digital technology
- Energy
- Environment
- Sustainability
We have designed a phone case that can charge your phone using the sun. We aim to allow everyone to easily access renewable, clean energy. We also believe this will encourage people to go outside and can also be used if your phone has ran out in an emergency. This can also allow people to save money on electric bills.
Our aim for this project is to make an affordable, accessible, way to access the internet, regardless of where, or who you are. We want to create an eco friendly solution to this problem, and a solution that works well and fast.
Throughout this project we have worked together strongly as a team and as a result we have made lots of great memories and have produced something we believe will make a great difference to the environment!

StaySafe
- Digital technology
- Education
My project is an application intended to teach knife crime and cyberbullying to secondary school students.

StaySafe
- Digital technology
- Education
My project is an application intended to teach knife crime and cyberbullying to secondary school students. I observed that most young people are unclear or do not understand these problems, I wanted to create a simple and engaging way to inform them. To accomplish this, I designed an interactive app that incorporates basic information, real-life scenarios, and helpful resources. The idea was to make learning easy and applicable, and thus enable students to understand the risks and effects of knife crime and cyberbullying. In the end, my app effectively informs and provides young people with the information they need in order to stay safe and make wise decisions.
I was first tasked with creating an app, and I wished to tackle serious issues that impact young people nowadays. Knife crime is a real issue in the UK, with almost 50,000 serious knife crimes reported in England between July 2023 and June 2024.(statistics from GET-LICENSED.CO.UK). Shockingly, 57 people under the age of 25 were killed using a knife or sharp instrument during the year ending March 2024 (statistics from BENKINSELLA.ORG.UK). Another important problem is cyberbullying, and one in four under the age of 25 are currently being bullied in the UK (statistics from THEMIX.ORG.UK). Furthermore, 27% of student participants in schools and colleges in the UK had reported some type of cyberbullying (statistics CYBERCREW.UK). I was driven to develop an educational resource to help raise awareness and ensure safety. Through this experience, I gained experience in app development, collaboration, and creative problem-solving while tackling problems that I care about.
My favourite aspect of the project was witnessing the code actually function, particularly the data collection aspect, after encountering errors over and over. It was frustrating at times, but each issue solved and advancement made felt very fulfilling. I also enjoyed learning new concepts in coding and developing my problem-solving abilities. Debugging was a patience and perseverance lesson, and it was exciting to understand how small changes could make an enormous difference. Overall, creating something from scratch and watching it come to life was an amazing experience. It showed me how powerful technology is in addressing real-world issues, and it made me even more passionate about coding and problem-solving!

The JOAR Farm Concept
- Climate change
- Energy
- Environment
- Food
- Sustainability
We wanted to achieve a maximum efficiency farm that produces food and energy all year round, despite seasonal changes.

The JOAR Farm Concept
- Climate change
- Energy
- Environment
- Food
- Sustainability
We wanted to achieve a maximum efficiency farm that produces food and energy all year round, despite seasonal changes.
We have been friends throughout our school time and are very passionate about science. The big bang project was the perfect opportunity for us to co-operate in something we are all interested in. We utilised the teachings through our lessons such as biology when using the farming system and physics when using the bi-convex lens system. We even used aspects of geography in the locational decisions and environmental choices.
Our favourite part was a night in March when we all went to a team member's house and got takeaway and worked on the project together - probably one of the most fun nights we had ever had.

WaveSafe
WaveSafe aims to design a habitable living space providing protection from extreme weather conditions like tsunamis and floods.

WaveSafe
WaveSafe aims to design a habitable living space providing protection from extreme weather conditions like tsunamis and floods. It is designed to keep a neighbourhood secure by distributing one bunker per kilometre squared. These safe havens shelter citizens by their structural integrity, waterproofing, and buoyancy control features, along with air filtration, ventilation, and communication systems ensuring the safety and comfort of its occupants. The primary concept of this project is a prototype design that offers both short-term survival and long-term resilience. Our materials are selected based on their competence and price, to keep cost-effectiveness and the high quality people deserve.
The inspiration for this project came from our geography lessons. In 2018, there was a huge flood caused by a tsunami which killed more than 300 people, 80% of which were elderly who had no means of escaping out. On back of this, we brainstormed to see how this can be prevented and people rescued in these conditions, forming the basis for this project.
The best part was working together to create the project, the brainstorming, making the model, researching the materials and all the various elements of it!

SmartSort
- Climate change
- Digital technology
- Education
- Environment
- Sustainability
Smart Sort has the potential to transform the way we approach recycling!

SmartSort
- Climate change
- Digital technology
- Education
- Environment
- Sustainability
By scanning QR codes on packages, my product identifies the material composition of each product and provides recycling instructions using an LCD display. This makes recycling effortless and efficient, regardless of local council rules. If widely adopted, Smart Sort has the potential to transform the way we approach recycling, making it more accessible for everyone.
After discovering the devastating effects poor recycling can have for wildlife and the environment, particularly the Great Pacific Garbage Patch, I was driven to create a solution. I researched various concepts such as the Pfand Machines in Germany and different scanning options such as RFID tags before settling on QR codes. QR codes are already widely used and are a simple and cost-effective way to store information making them ideal to implement for my scanning method.
My initial idea was having a 5-compartment bin that users could use to split their recycling. I’ve since adapted this design for a console-style system such as an AlexaEcho that users can put anywhere in their home to scan and sort their recycling with ease. This solution ensures effective recycling whilst encouraging more sustainable habits. I used a Raspberry Pi 4 Model B because its powerful processing was ideal for the quick scanning and data retrieval needed for this project. The outcome? Smart Sort successfully identifies different materials and gives clear feedback to the user using the LCD display. The LCD display directs the user to the correct recycling method for the product.
Although this product is still in development, it has the potential to largely increase recycling rates and reduce landfill waste. SmartSort could also be enhanced by using them beyond household use, or in the workplace.
Sorry, no entries could be found. Please adjust your search criteria.
